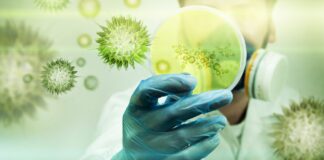
Variante D614G del SARS-CoV-2

“Juntos por Kata”. “Ayudemos a que Kata vuelva a casa”. Los mensajes en pancartas y redes sociales se multiplican mientras continúa la búsqueda desesperada de Kataleya Álvarez, la niña peruana desaparecida en Florencia, Italia.
No hay rastro de la menor desde el 10 de junio, cuando fue vista saliendo con unos niños del edificio donde residía y volviendo a entrar al lugar sola minutos después.
Su madre fue quien sonó la alarma cuando al regresar de su trabajo no encontró a la menor.
Kataleya nació en Perú pero llegó a Italia con su familia a los seis meses de edad. La niña vivía con su madre y otros familiares en el antiguo hotel Astor.
El edificio está ocupado ilegalmente desde septiembre de 2022 por inmigrantes, en su mayoría latinoamericanos y rumanos. La policía italiana ha montado un extenso operativo en busca de la niña. Y la comunidad latinoamericana en Florencia realizó varias marchas en la calle pidiendo que se encuentre a la menor.
Leer también [Los 5 tripulantes del Submarino Titán fallecieron por “implosión” de la nave]
Qué se sabe sobre la desaparición de Kataleya
Una funcionaria del consulado de Perú en Florencia señaló que el consulado no está en contacto con los padres de la niña, Katherine Álvarez y Miguel Angel Romero, porque ambos “se encuentran bajo custodia policial para protegerlos”.
La funcionaria agregó que las autoridades solicitaron al Cónsul de Perú en la ciudad italiana que no haga declaraciones “para no entorpecer la investigación”. La policía italiana desalojó el exhotel Astor y realizó el domingo y lunes un examen exhaustivo del interior del edificio con expertos forenses.
La Nazione, un periódico de Florencia, señaló que los padres de Kataleya regresaron al antiguo hotel para asistir a la inspección junto al general Luciano Garofano, excomandante del Ris (Departamento de Investigaciones Científicas de la policía italiana), quien asesora a la familia.
El general Garofano señaló que le parecía “bastante obvio que la niña fue secuestrada”.
Pero agregó: “No nos pregunten qué pasó, si sigue viva, cuál fue el propósito, porque nadie lo puede decir y sería grave hacer suposiciones sobre las que no tenemos elementos”, informó La Nazione.
Algunos reportes en la prensa local indican que la niña habría sido vista tras su desaparición en compañía de un adulto, pero esta información no fue confirmada por la policía italiana.
Varios medios italianos indican que el antiguo hotel Astor, donde vivían más de 100 inmigrantes que alquilaban cuartos en el lugar, ha sido escenario de disputas e incidentes violentos. Pero no se sabe si esos hechos estarían vinculados de alguna forma a la desaparición de la menor.
En uno de los incidentes más recientes, el 28 de mayo, un hombre ecuatoriano se lanzó desde la ventana de su habitación y dijo posteriormente que fue amenazado con cuchillos por otros inmigrantes.
Algunos informes en medios locales citan a exresidentes del antiguo hotel que aseguraron que el comportamiento y “la bulla” constante de algunos ocupantes era motivo de disputas.
Leer también [Hombre violaba cadáveres de sus víctimas y confesó el crimen de 48 personas]
Movilización de la comunidad
En Perú, el abuelo materno de la niña, David Álvarez Escalante, habló de la desesperación de su hija por encontrar a la niña y pidió ayuda financiera al gobierno peruano para viajar a Florencia.
“Me siento preocupado y desesperado en esta situación. Mi pedido es un vuelo humanitario hacia Italia para poder ayudar a mi hija, para estar a su lado. Yo como padre y abuelo tengo que ayudar a buscarla”, declaró.
La comunidad latinoamericana en la ciudad italiana ha venido organizando diversas marchas para pedir que se encuentre a la menor. Juan Manuel Núñez Rubio, capellán de la comunidad latinoamericana en Florencia, anunció que el arzobispo de Florencia, Giuseppe Betori, pidió a la gente que ore por la niña desaparecida.
«Esta desaparición ha movilizado a muchas personas llenas de buena voluntad que con valentía se comprometieron desde el primer momento en que supieron de la desaparición, se juntaron e iniciaron la búsqueda», añadió el capellán.
«La desaparición entristeció no solo a los peruanos presentes en Florencia, sino también a toda la comunidad florentina, incluso del exterior, en particular del Perú».
A pocos días de iniciado el operativo de búsqueda, la madre de Kataleya dio un mensaje en medios locales que sigue vigente. Entre lágrimas, Katherine Álvarez dijo:“No importa por qué, por qué se llevaron a mi hija, pero déjenla ir. Donde quieran, en un parque, en una iglesia… Por favor, déjenla ir. Por favor”.